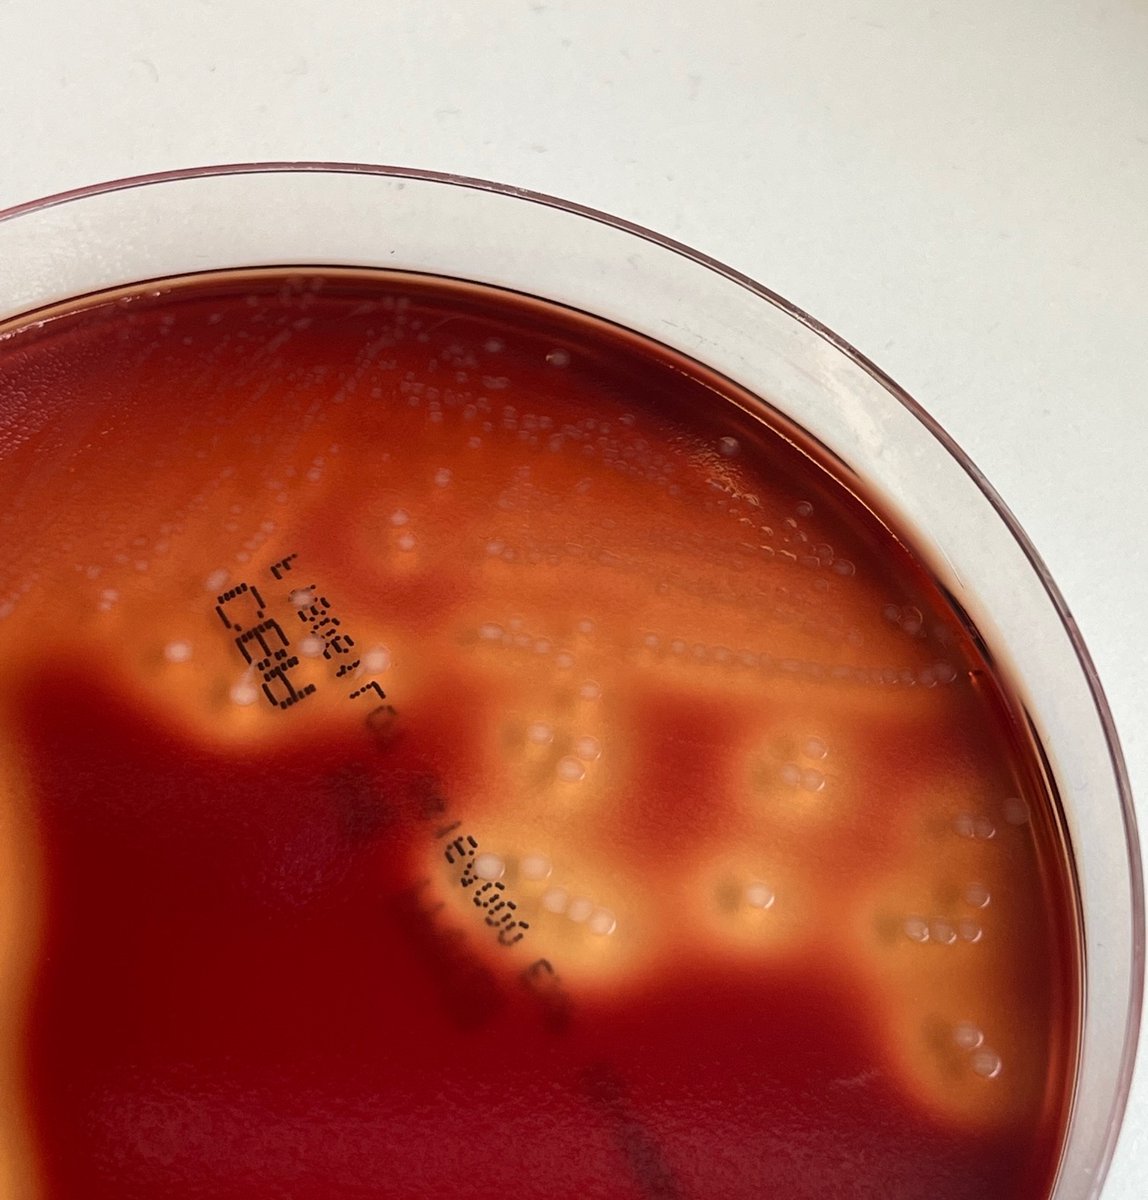
Valerie Soo tweet media

David M. McCandlish
528 posts

David M. McCandlish
@TheDMMcC
Mathematical biologist, assistant professor Cold Spring Harbor Laboratory


Very excited to share our preprint @PalashSethi6 "Importance of higher-order epistasis in large protein sequence-function relationships" biorxiv.org/content/10.110…






📢Clonal hematopoiesis driven by mCAs📢What fitness effects do mCAs confer to our blood cells?🩸 How often do they occur? Does an mCA’s fitness correlate with blood cancer risk?🔎Read mine & @jrblundell's latest paper @NatureGenet to find out (& more!):👉🔗rdcu.be/dlRRr



Faculty job alert! CSHL is hiring a faculty position in computational neuroscience, broadly defined. Deadline to apply is Sept 1, 2023 (the earlier the better). cshl.edu/about-us/caree… Yes, I snapped this view today, a 1 min walk from your new office!